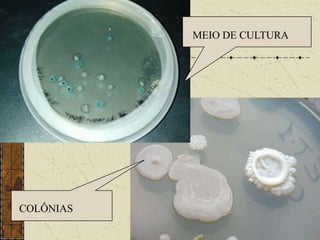
Peptona
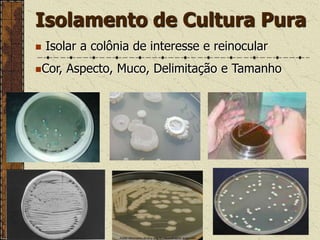
Ágar

O documento discute os requisitos e preparação de meios de cultura, incluindo fatores como pH, temperatura, nutrientes e consistência necessários para o crescimento de microrganismos. Ele também classifica e exemplifica diferentes tipos de meios de cultura, descreve técnicas de inoculação e fornece recomendações para o controle de qualidade.





![Semi-Sólido: Presença de nutrientes e Ágar em [ ] menor que 15g/1000ml;](https://image.slidesharecdn.com/aula3-preparaodemeiosdecultura-110227085659-phpapp02/85/Aula-3-M-6-320.jpg)
![Sólido: Presença de nutrientes e Ágar em [ ] maior que15g/1000ml.Classificação dos Meios de CulturaQuanto à FunçãoEnriquecedor: Permite o crescimento de microrganismos que necessitam de fatores de crescimento, mas não inibem o crescimento de outros;](https://image.slidesharecdn.com/aula3-preparaodemeiosdecultura-110227085659-phpapp02/85/Aula-3-M-7-320.jpg)